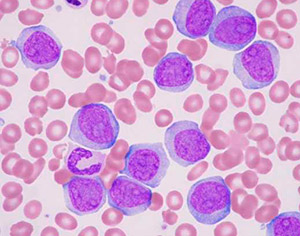

Что такое лимфоциты?
Лимфоциты – клетки крови, играющие ключевую роль в иммунной системе. Они являются подтипом лейкоцитов, известных как «белые кровяные тельца», и обеспечивают гуморальный и клеточный иммунитет, регулируя активность других клеток. В организме человека лишь 2% лимфоцитов находятся в кровотоке, остальные 98% располагаются в органах и тканях, защищая от неблагоприятных факторов.
Продолжительность жизни лимфоцитов варьируется от нескольких часов до десятков лет.
Формирование лимфоцитов происходит в лимфоидных органах, которые делятся на центральные и периферические.
К центральным органам относятся красный костный мозг и тимус (вилочковая железа).
Костный мозг расположен в телах позвонков, костях таза, черепа, грудине, рёбрах и трубчатых костях. Он является основным органом кроветворения на протяжении всей жизни. Гемопоэтическая ткань производит молодые клетки, которые сразу поступают в кровоток, не накапливаясь в костном мозге.
Тимус – орган лимфопоэза, наиболее активный в детском возрасте, расположен в верхней части грудной клетки, позади грудинной кости. С началом половой зрелости тимус уменьшается в размерах. Кора тимуса на 85% состоит из лимфоцитов, что дало название «Т-лимфоцит». Эти клетки выходят из тимуса незрелыми и продолжают созревание в периферических органах лимфопоэза. На функции тимуса влияют возраст, стресс и применение глюкокортикоидов.
Периферическими органами лимфопоэза являются селезёнка, лимфатические узлы и лимфоидные скопления в органах желудочно-кишечного тракта, известные как «пейеровы» бляшки. Эти органы заполнены Т и В-лимфоцитами и играют важную роль в иммунной системе.
Лимфоциты – уникальная группа клеток с разнообразием и специфическими функциями. Это округлые клетки с преобладающим ядром. Набор ферментов и активных веществ в лимфоцитах варьируется в зависимости от их роли. Все лимфоциты делятся на две основные группы: Т и В.
Т-лимфоциты имеют общее происхождение и схожее строение, но выполняют разные функции. Среди них выделяют клетки, реагирующие на антигены, клетки, участвующие в аллергических реакциях, помощники (хэлперы), атакующие клетки (киллеры), супрессоры и клетки памяти, запоминающие чуждые вещества для быстрого распознавания при повторном контакте.
В-лимфоциты также происходят из костного мозга, но имеют широкий спектр функций. Среди них можно выделить киллеров, супрессоров и клетки памяти. Основную массу В-лимфоцитов составляют клетки, вырабатывающие иммуноглобулины, которые отвечают за гуморальный иммунитет и участвуют в клеточных реакциях.
Хронический лимфолейкоз (ХЛЛ) представляет собой злокачественное заболевание, которое затрагивает лимфатическую систему. Врачи отмечают, что симптомы могут быть неявными на ранних стадиях и включают усталость, увеличение лимфатических узлов, ночные поты и частые инфекции. Причины развития ХЛЛ до конца не изучены, однако генетические факторы и воздействие определенных химических веществ могут играть роль. Лечение заболевания варьируется в зависимости от стадии и может включать химиотерапию, иммунотерапию и таргетную терапию. Прогноз для пациентов с ХЛЛ в последние годы значительно улучшился благодаря новым методам лечения, однако он зависит от индивидуальных особенностей и общего состояния здоровья пациента. Врачи подчеркивают важность регулярного мониторинга и своевременного обращения за медицинской помощью для достижения наилучших результатов.

Что такое хронический лимфолейкоз?
Слово «лейкоз» обозначает онкологическое заболевание, затрагивающее систему кроветворения. В нормальных клетках крови возникают атипичные клетки с изменённой структурой генов, которые бесконечно делятся и вытесняют здоровые клетки. Прогрессирование болезни приводит к накоплению этих клеток в органах и тканях, нарушая их функции.
Лимфолейкоз – разновидность лейкоза, затрагивающая лимфоциты. Атипичные клетки формируются среди лимфоцитов, теряя основную функцию – защиту организма от инфекций. Вытеснение нормальных лимфоцитов ослабляет иммунную систему, делая организм уязвимым к инфекциям и бактериям.
Хронический лимфолейкоз развивается медленно. Первые симптомы проявляются на поздних стадиях, когда атипичных клеток становится больше, чем нормальных. На ранних стадиях болезнь чаще всего выявляется во время планового анализа крови, где наблюдается увеличение общего количества лейкоцитов за счёт лимфоцитов.
Нормальные лимфоциты составляют 19-37% от общего числа лейкоцитов. На поздних стадиях лимфолейкоза этот показатель может достигать 98%. Однако новые лимфоциты не выполняют своих функций, и иммунный ответ ослабляется. Поэтому хронический лимфолейкоз часто сопровождается инфекциями, которые протекают тяжелее, чем у здоровых людей.
Причины хронического лимфолейкоза
Связь хронического лимфолейкоза с традиционными канцерогенными факторами не установлена. Это заболевание является единственным лейкозом, не связанным с ионизирующим излучением.
Основная теория возникновения хронического лимфолейкоза связана с генетическими изменениями. Исследования показывают, что в хромосомах лимфоцитов происходят изменения, связанные с их неконтролируемым делением. При воздействии неустановленных факторов на предшественницу В-лимфоцитов происходят изменения, нарушающие нормальное функционирование. Эта клетка начинает активно делиться, создавая «клон атипичных клеток». Новые клетки созревают, но не выполняют необходимых функций. Мутации генов могут происходить и в атипичных лимфоцитах, что приводит к образованию субклонов и более агрессивному течению заболевания.
С развитием болезни раковые клетки заменяют нормальные лимфоциты и другие клетки крови. Лимфоциты участвуют в различных клеточных реакциях и влияют на рост других клеток. При замещении их атипичными клетками наблюдается подавление деления клеток-предшественниц эритроцитарного и миелоцитарного рядов. Аутоиммунный механизм также вовлекается в разрушение здоровых клеток крови.
Существует предрасположенность к хроническому лимфолейкозу, которая может передаваться по наследству. Хотя учёные не определили точный набор генов, повреждённых при этом заболевании, статистика показывает, что в семьях с хотя бы одним случаем хронического лимфолейкоза риск заболевания у родственников возрастает в 7 раз.
Симптомы хронического лимфолейкоза
На ранних стадиях симптомы отсутствуют. Болезнь может развиваться годами без явных признаков, лишь с изменениями в общем анализе крови. Количество лейкоцитов на начальных этапах заболевания находится на верхней границе нормы.
Первые признаки неспецифичны и включают слабость, утомляемость, недомогание, потерю веса и повышенную потливость. С развитием болезни проявляются более характерные признаки.
| Симптом | Проявление | Механизм возникновения |
| Увеличение лимфатических узлов | Увеличение лимфатических узлов, плотные, безболезненные, с «тестоватой» консистенцией. Увеличение глубоких лимфатических узлов можно обнаружить при УЗИ. | Увеличение количества лимфоцитов в крови приводит к их инфильтрации лимфатических узлов, вызывая их увеличение. |
| Спленомегалия и гепатомегалия | Увеличение селезёнки и печени, неприятные ощущения в области подреберья, возможна желтуха. | Увеличение количества лимфоцитов инфильтрует органы и ткани. |
| Анемия, тромбоцитопения и гранулоцитопения | Анемия проявляется бледностью кожи, головокружениями, снижением выносливости. Снижение тромбоцитов ведёт к нарушению свёртываемости крови. Снижение гранулоцитов приводит к инфекционным осложнениям. | Чрезмерная пролиферация лимфоидной ткани в костном мозгу замещает другие элементы, нарушая деление и созревание клеток крови. |
| Снижение иммунной активности | Склонность к частым инфекционным заболеваниям, которые протекают тяжелее и дольше. | Ослабление иммунитета связано с заменой нормальных лимфоцитов атипичными клетками. |
| Аутоиммунные осложнения | Проявляются гемолитической анемией и тромбоцитопенией, что может привести к гемолитическому кризу и повышенному риску опасных кровотечений. | Связаны с образованием антител к элементам гемопоэтической ткани и клеткам крови, что приводит к их разрушению. |
Диагностика хронического лимфолейкоза
Диагностика хронического лимфолейкоза обычно не вызывает затруднений. Проблемы могут возникнуть при дифференциальной диагностике с другими лимфопролиферативными опухолями. Основные анализы включают:
- Общий анализ крови
- Миелограмма
- Биохимический анализ крови
- Анализ на наличие клеточных маркеров (иммунофенотипирование)
| Анализ | Цель исследования | Интерпретация результатов |
| Общий анализ крови | Выявление повышенного количества лейкоцитов и лимфоцитов | Увеличение лимфоцитов более 5×10^9/л указывает на вероятность хронического лимфолейкоза. |
| Миелограмма | Выявление замещения клеток красного костного мозга лимфопролиферативной тканью | В начале заболевания содержание лимфоцитов в костном мозге около 50%, с прогрессированием увеличивается до 98%. |
| Биохимический анализ крови | Выявление отклонений в работе иммунной системы и других органов | На ранних стадиях отклонений не отмечается, позже могут проявляться гипопротеинемия и гипогаммаглобулинемия. |
| Иммунофенотипирование | Выявление специфических клеточных маркеров хронического лимфолейкоза | На поверхности атипичных лимфоцитов обнаруживаются антигены CD5, CD19 и CD23. |
Для подтверждения диагноза часто применяются биопсия лимфатического узла с гистологическим исследованием, цитогенетическое исследование, УЗИ и компьютерная томография. Эти методы помогают выявить различия между хроническим лимфолейкозом и другими заболеваниями, а также определить распространённость и прогрессирование болезни.
| Стадии ХЛЛ поRai | Стадии ХЛЛ поBinet |
| 0 – абсолютный лимфоцитоз более 5×10^9/л, отсутствие других симптомов; I – лимфоцитоз с увеличением лимфатических узлов; II – лимфоцитоз с увеличением селезёнки или печени; III – лимфоцитоз с снижением гемоглобина менее 100 г/л; IV – лимфоцитоз с тромбоцитопенией менее 100×10^9/л. | А – уровень гемоглобина более 100 г/л, уровень тромбоцитов более 100×10^9/л; В — уровень гемоглобина более 100 г/л, уровень тромбоцитов более 100×10^9/л; С — уровень гемоглобина менее 100 г/л, уровень тромбоцитов менее 100×10^9/л. |
Лечение хронического лимфолейкоза
Хронический лимфолейкоз не поддаётся полному излечению, но при своевременной диагностике и терапии можно значительно улучшить качество и продолжительность жизни. Даже при высококачественном лечении болезнь может медленно прогрессировать.
На начальных стадиях специальное лечение не требуется. Состояние пациента находится под наблюдением врача-гематолога. Показанием для начала терапии является значительное прогрессирование болезни или ухудшение состояния пациента.
| Препарат | Механизм действия | Способ применения | Эффективность |
| Флударабин | Цитостатический препарат | 25 мг/м² внутривенно в течение трёх дней | Наиболее эффективный пуриновый аналог. Полные ремиссии достигаются у большинства пациентов. |
| Циклофосфамид | Противоопухолевое, цитостатическое действие | 250 мг/м² внутривенно в течение трёх дней | В сочетании с другими препаратами образует эффективные схемы лечения. |
| Ритуксимаб | Моноклональные антитела к антигену CD20 | 375 мг/м² раз в три недели | В сочетании с цитостатиками повышает вероятность достижения ремиссий. |
| Хлорамбуцил | Алкилирующее вещество | От 2 до 10 мг в сутки в течение 4-6 недель | Эффективный цитостатик с избирательным действием на лимфоидную опухолевую ткань. |
Лечение хронического лимфолейкоза является комплексным, применяются следующие комбинации препаратов:
- «FCR» — флударабин, циклофосфамид, ритуксимаб – высокоэффективная схема лечения;
- Хлорамбуцил + ритуксимаб – используется при наличии соматических заболеваний;
- «СОР» — циклофосфамид, винкристин, преднизолон – назначается при прогрессировании заболевания;
- «СНОР» — циклофосфамид, винкристин, преднизолон, адриабластин – применяется при отсутствии эффективности программы «СОР».
Лучевая терапия необходима при увеличении лимфатических узлов или селезёнки, лимфоцитарной инфильтрации нервных стволов, а также при высоком уровне лимфоцитов в крови в сочетании с анемией и тромбоцитопенией. Она используется для локального облучения инфильтрированного органа на поздних стадиях заболевания.
Удаление селезёнки является малоефективным методом при выраженной цитопении и отсутствии эффективности лечения глюкокортикоидами.
Прогноз при хроническом лимфолейкозе
Не зафиксировано случаев полного выздоровления от хронического лимфолейкоза. Продолжительность жизни пациентов зависит от состояния здоровья, пола, возраста, своевременности диагностики и эффективности лечения, варьируется от нескольких месяцев до десятков лет.
- Полная ремиссия – отсутствие симптомов интоксикации, нормальные размеры лимфатических узлов, селезёнки и печени, содержание гемоглобина более 100 г/л, нейтрофилов более 1,5×10^9/л, тромбоцитов более 100×10^9/л. |
- Частичная ремиссия – состояние, при котором количество лимфоцитов удаётся снизить на 50%, размеры селезёнки и лимфатических узлов уменьшаются в два раза. |
- Прогрессирование болезни – отсутствие улучшения после лечения, ухудшение состояния пациента, увеличение тяжести симптомов. |
- Стабильное течение заболевания – отсутствие признаков улучшения или ухудшения состояния пациента. |
При использовании схем «СОР» или «СНОР» полные ремиссии достигаются у 30-50% пациентов, но они кратковременны. Программа «FCR» приводит к ремиссии примерно в 95% случаев, длительность которой может составлять до двух лет.
| Симптом | Причина | Лечение/Управление |
|---|---|---|
| Увеличение лимфатических узлов (безболезненное) | Клонирование злокачественных В-лимфоцитов | Наблюдение (для ранних стадий), химиотерапия, таргетная терапия (например, ингибиторы BTK, PI3K), иммунотерапия (например, моноклональные антитела), трансплантация стволовых клеток |
| Увеличение селезенки (спленомегалия) | Накопление злокачественных лимфоцитов в селезенке | Спленэктомия (в некоторых случаях), химиотерапия, таргетная терапия |
| Утомляемость, слабость | Анемия, вызванная замещением костного мозга, повышенное потребление энергии организмом | Трансфузии крови, лечение основной причины (химиотерапия, таргетная терапия) |
| Потеря веса | Повышенный метаболизм, снижение аппетита | Поддержка питания, лечение основной причины |
| Ночная потливость | Повышенная активность иммунной системы | Лечение основной причины, симптоматическая терапия |
| Лихорадка | Инфекции, связанные с иммуносупрессией | Лечение инфекций, профилактика инфекций |
| Частые инфекции | Иммуносупрессия, вызванная замещением костного мозга | Профилактика инфекций (вакцинация, антибиотики), лечение основной причины |
| Кожный зуд | Неизвестен, возможно связан с накоплением лимфоцитов в коже | Антигистаминные препараты, лечение основной причины |
| Кровотечения | Тромбоцитопения (снижение уровня тромбоцитов) | Трансфузии тромбоцитов, лечение основной причины |
| Боль в костях | Накопление лимфоцитов в костном мозге | Анальгетики, бисфосфонаты |
Хронический лимфолейкоз (ХЛЛ) — это заболевание, которое вызывает много вопросов и беспокойства у пациентов и их близких. Люди часто отмечают, что первые симптомы могут быть незаметными: усталость, увеличение лимфатических узлов, потливость и частые инфекции. Эти проявления порой списываются на обычное недомогание, что затягивает диагностику. Причины ХЛЛ до конца не изучены, но генетические факторы и воздействие определенных химических веществ могут играть роль. Лечение включает наблюдение, химиотерапию и иммунотерапию, что вызывает разные мнения о его эффективности. Прогноз для пациентов варьируется: некоторые живут много лет с минимальными симптомами, в то время как другие сталкиваются с более агрессивной формой болезни. Важно, чтобы пациенты получали поддержку и информацию, чтобы справляться с этим диагнозом.

Причины хронического лимфолейкоза
В отличие от других видов рака, связь хронического лимфолейкоза с традиционными канцерогенными факторами не установлена. Это единственный лейкоз, не связанный с ионизирующим излучением.
Основная гипотеза о возникновении хронического лимфолейкоза основана на генетических факторах. Исследования показывают, что с прогрессированием болезни в хромосомах лимфоцитов происходят изменения, связанные с неконтролируемым делением и ростом клеток. Поэтому при клеточном анализе наблюдается разнообразие клеточных вариантов лимфоцитов.
Под воздействием неустановленных факторов в предшественнице В-лимфоцитов происходят изменения в генетическом материале, нарушающие нормальные функции клетки. В результате она начинает активно делиться, формируя «клон атипичных клеток». Новые клетки созревают в лимфоциты, но не выполняют своих функций. Мутации генов могут происходить и в атипичных лимфоцитах, что приводит к образованию субклонов и более агрессивному течению заболевания.
С прогрессированием болезни раковые клетки заменяют нормальные лимфоциты и другие клетки крови. Лимфоциты, помимо иммунных функций, участвуют в клеточных реакциях и влияют на рост других клеток. Замещение их атипичными клетками подавляет деление клеток-предшественниц эритроцитарного и миелоцитарного рядов. Также аутоиммунный механизм вовлекается в разрушение здоровых клеток крови.
Существуют наследственные факторы предрасположенности к хроническому лимфолейкозу. Хотя учёные не определили точный набор генов, повреждаемых при этом заболевании, статистика показывает, что в семьях с хотя бы одним случаем хронического лимфолейкоза риск заболевания у родственников увеличивается в 7 раз.
Симптомы хронического лимфолейкоза
На ранних стадиях заболевания симптомы едва заметны. Болезнь может развиваться годами без явных признаков, лишь с небольшими изменениями в общем анализе крови. На начальных этапах уровень лейкоцитов остается в пределах нормы.
Первые проявления заболевания не специфичны для хронического лимфолейкоза и включают общие симптомы: слабость, утомляемость, недомогание, потерю веса и повышенное потоотделение. По мере прогрессирования болезни появляются более характерные симптомы.
| Симптом | Проявление | Механизм возникновения |
| Увеличение лимфатических узлов | При осмотре можно заметить увеличение лимфатических узлов, которые становятся плотными, безболезненными и имеют «тестоватую» консистенцию. Увеличение глубоких лимфатических узлов (внутригрудных и внутрибрюшных) выявляется с помощью УЗИ. | Увеличение числа лимфоцитов в крови приводит к их инфильтрации лимфатических узлов, что вызывает увеличение и уплотнение. |
| Увеличение селезёнки и печени | Увеличение селезёнки и печени часто сопровождается тяжестью и болью в правом и левом подреберьях, возможна желтуха. При пальпации можно прощупать селезёнку и определить смещение границ печени. | Процесс связан с увеличением лимфоцитов, инфильтрующих органы и ткани. |
| Анемия, тромбоцитопения и гранулоцитопения | Анемия проявляется бледностью кожи, головокружением, снижением выносливости и слабостью. Снижение тромбоцитов нарушает свёртываемость, увеличивая время кровотечения и вызывая геморрагические высыпания (петехии, экхимозы). Снижение гранулоцитов может привести к инфекционным осложнениям. | Пролиферация лимфоидной ткани в костном мозгу замещает другие элементы гемопоэтической ткани, нарушая деление и созревание клеток крови. |
| Снижение иммунной активности | Основное проявление нарушений иммунной системы — предрасположенность к частым инфекциям. Из-за слабой защиты такие болезни протекают тяжелее и с осложнениями. | Ослабление иммунитета связано с заменой нормальных лимфоцитов «атипичными» клетками, которые не выполняют их функции. |
| Аутоиммунные осложнения | Аутоиммунные процессы при хроническом лимфолейкозе чаще всего проявляются гемолитической анемией и тромбоцитопенией, что может привести к гемолитическому кризу (острая анемия, повышение температуры, увеличение билирубина в крови, резкое ухудшение состояния) и повышенному риску опасных для жизни кровотечений. | Эти симптомы связаны с образованием антител к элементам гемопоэтической ткани и клеткам крови, что приводит к их разрушению. |

Диагностика хронического лимфолейкоза
В большинстве случаев диагностика хронического лимфолейкоза проходит без трудностей, однако могут возникнуть сложности при его дифференциации от других лимфопролиферативных опухолей. Основные анализы для диагностики включают:
- Общий анализ крови
- Миелограмма
- Биохимический анализ крови
- Исследование на клеточные маркеры (иммунофенотипирование)
| Анализ | Цель исследования | Интерпретация результатов |
| Общий анализ крови | Определение уровня лейкоцитов и лимфоцитов | Увеличение лимфоцитов выше 5×10^9/л может указывать на хронический лимфолейкоз. Возможны лимфобласты и пролимфоциты. Регулярный анализ может показать медленно прогрессирующий лимфоцитоз, вытесняющий другие клетки (70-90%), а на поздних стадиях – и другие элементы крови (анемия, тромбоцитопения). Полуразрушенные ядра лимфоцитов, известные как тени Гумпрехта, являются характерным признаком. |
| Миелограмма | Определение замещения клеток красного костного мозга | На начальном этапе содержание лимфоцитов в костном мозге около 50%. При прогрессировании может возрасти до 98%. Возможен умеренный миелофиброз. |
| Биохимический анализ крови | Определение отклонений в функционировании органов | На ранних стадиях отклонений может не быть. Позже могут проявляться гипопротеинемия и гипогаммаглобулинемия. При инфильтрации печени возможны изменения в печеночных пробах. |
| Иммунофенотипирование | Определение клеточных маркеров хронического лимфолейкоза | На «атипичных» лимфоцитах выявляются антигены CD5, CD19 и CD23. Иногда наблюдается снижение В-клеточных маркеров CD20 и CD79b, а также слабая экспрессия IgM и IgG. |
Для подтверждения диагноза хронического лимфолейкоза применяются биопсия лимфатического узла с гистологическим анализом, цитогенетическое исследование, УЗИ и компьютерная томография. Эти методы помогают выявить отличия от других лимфопролиферативных заболеваний, обнаружить инфильтрацию лимфоцитами и оценить распространенность болезни для выбора эффективного лечения.
| Стадии ХЛЛ поRai | Стадии ХЛЛ поBinet |
| * 0 – абсолютный лимфоцитоз более 5×10^9/л, отсутствие симптомов; низкий риск; выживаемость более 10 лет. * I – лимфоцитоз с увеличением лимфатических узлов; промежуточный риск; выживаемость 7 лет. * II – лимфоцитоз с увеличением селезёнки или печени; промежуточный риск; выживаемость 7 лет. * III – лимфоцитоз с гемоглобином ниже 100 г/л; высокий риск; выживаемость 1,5 года. * IV – лимфоцитоз с тромбоцитопенией менее 100×10^9/л; высокий риск; выживаемость 1,5 года. | * А – гемоглобин выше 100 г/л, тромбоциты более 100×10^9/л; менее трёх зон поражения; выживаемость более 10 лет. * В – гемоглобин выше 100 г/л, тромбоциты более 100×10^9/л; более трёх зон поражения; выживаемость 7 лет. * С – гемоглобин ниже 100 г/л, тромбоциты ниже 100×10^9/л; любое количество зон поражения; выживаемость 1,5 года. * Зоны поражения – голова, шея, подмышечные и паховые области, селезёнка, печень. |
Лечение хроническоголимфолейкоза
К сожалению, хронический лимфолейкоз не поддается полному излечению, но ранняя диагностика и правильная терапия могут значительно улучшить продолжительность и качество жизни пациентов. Даже при высококачественном лечении заболевание может медленно прогрессировать.
На начальных стадиях специальное лечение не требуется. В этот период состояние пациента контролируется врачом-гематологом. При стабильном течении пациент может чувствовать себя хорошо без медикаментов. Начало терапии происходит при значительном прогрессировании болезни (увеличение лимфоцитов в крови, рост лимфатических узлов или селезёнки), ухудшении состояния или появлении осложнений.
| Препарат | Механизм действия | Способ применения | Эффективность |
| Флударабин | Цитостатик из группы пуриновых аналогов | 25 мг/м² внутривенно в течение трёх дней. Интервал между курсами – один месяц | Наиболее эффективный пуриновый аналог. Большинство пациентов достигает полной ремиссии. Рекомендуется комбинировать с другими цитостатиками для продления ремиссии |
| Циклофосфамид | Противоопухолевый, цитостатический, иммунодепрессивный, алкилирующий препарат | 250 мг/м² внутривенно в течение трёх дней | В сочетании с другими средствами образует эффективные схемы лечения с минимальными побочными эффектами |
| Ритуксимаб | Моноклональные антитела к антигену CD20 | 375 мг/м² раз в три недели | В комбинации с цитостатиками увеличивает шансы на полные и длительные ремиссии |
| Хлорамбуцил | Алкилирующее вещество, блокирующее синтез ДНК | 2-10 мг в сутки в течение 4-6 недель | Эффективный цитостатик с избирательным действием на лимфоидные опухоли |
Лечение хронического лимфолейкоза включает комплексный подход с использованием следующих комбинаций препаратов:
- «FCR» — флударабин, циклофосфамид, ритуксимаб – наиболее распространённая и эффективная схема терапии;
- Хлорамбуцил + ритуксимаб – применяется при сопутствующих заболеваниях;
- «СОР» — циклофосфамид, винкристин, преднизолон – курс повторяется каждые 3 недели, всего 6-8 циклов, назначается при прогрессировании болезни на фоне других методов лечения;
- «СНОР» — циклофосфамид, винкристин, преднизолон, адриабластин – используется при отсутствии эффекта от схемы «СОР».
Лучевая терапия необходима при увеличении лимфатических узлов или селезёнки, лимфоцитарной инфильтрации нервных стволов и других органов, а также при высоком уровне лимфоцитов в крови в сочетании с анемией и тромбоцитопенией. Она применяется для локального облучения поражённого органа на поздних стадиях заболевания или при неэффективности медикаментозного лечения.
Удаление селезёнки, хотя и малоеэффективно, может быть применено при выраженной цитопении, отсутствии результата от лечения глюкокортикоидами и значительном увеличении селезёнки.
Прогноз при хроническомлимфолейкозе
На данный момент не зафиксировано случаев полного выздоровления от хронического лимфолейкоза. Продолжительность жизни пациентов зависит от множества факторов: общего состояния здоровья, пола, возраста, своевременности диагностики и эффективности лечения. Она может варьироваться от нескольких месяцев до десятков лет.
- Полная ремиссия – состояние, при котором отсутствуют симптомы интоксикации, размеры лимфатических узлов, селезёнки и печени нормальные, уровень гемоглобина превышает 100 г/л, количество нейтрофилов более 1,5×10^9/л, а тромбоцитов – более 100×10^9/л. Миелограмма должна быть нормальной (лимфоидная ткань в биоптате не превышает 30%), и это состояние должно сохраняться не менее двух месяцев.
- Частичная ремиссия – состояние, продолжающееся не менее двух месяцев, характеризующееся снижением количества лимфоцитов в крови на 50% и уменьшением размеров селезёнки и лимфатических узлов вдвое. Показатели гемоглобина, нейтрофилов и тромбоцитов должны соответствовать полной ремиссии или увеличиться на 50% по сравнению с анализами до лечения.
- Прогрессирование болезни – диагностируется при отсутствии улучшений после лечения, ухудшении состояния пациента, увеличении тяжести симптомов и появлении новых признаков, а также переходе заболевания в более агрессивную форму.
- Стабильное течение заболевания – состояние, при котором не наблюдается ни улучшений, ни ухудшений.
При применении схем «СОР» или «СНОР» полные ремиссии достигаются у 30-50% пациентов, но они обычно кратковременны. Программа «FCR» обеспечивает ремиссию примерно в 95% случаев, с продолжительностью до двух лет.
Вопрос-ответ
Сколько живут люди с хроническим лимфолейкозом?
Продолжительность жизни пациентов с хроническим лимфолейкозом в последние годы значительно увеличилась. На сегодняшний день пятилетняя выживаемость, или вероятность прожить 5 или более лет с момента постановки диагноза, составляет 83%.
Каков прогноз хронического лимфолейкоза?
Течение хронического лимфобластного лейкоза сильно варьируется. Выживаемость колеблется в диапазоне от 2 до 20 лет, в среднем около 10 лет. Выживаемость без лечения больных 0–II стадий по классификации Rai составляет 5–20 лет.
Можно ли вылечить хронический лимфолейкоз?
Полностью вылечить хронический лимфолейкоз невозможно. При достижении ремиссии пациент должен регулярно проходить обследование у гематолога, избегать избыточной инсоляции и воздействия токсинов, вести здоровый образ жизни.
Советы
СОВЕТ №1
Регулярно проходите медицинские обследования. Хронический лимфолейкоз может развиваться незаметно, поэтому важно регулярно проверять уровень лейкоцитов и другие показатели крови, особенно если у вас есть предрасположенность к этому заболеванию.
СОВЕТ №2
Обратите внимание на симптомы. Если вы заметили такие признаки, как усталость, частые инфекции, увеличение лимфатических узлов или потливость, не откладывайте визит к врачу. Раннее выявление может значительно улучшить прогноз.
СОВЕТ №3
Изучите доступные методы лечения. Хронический лимфолейкоз может лечиться различными способами, включая химиотерапию, иммунотерапию и таргетную терапию. Обсудите с вашим врачом все возможные варианты и выберите наиболее подходящий для вас.
СОВЕТ №4
Поддерживайте здоровый образ жизни. Правильное питание, регулярные физические нагрузки и отказ от вредных привычек могут помочь укрепить иммунную систему и улучшить общее состояние здоровья, что особенно важно при хронических заболеваниях.